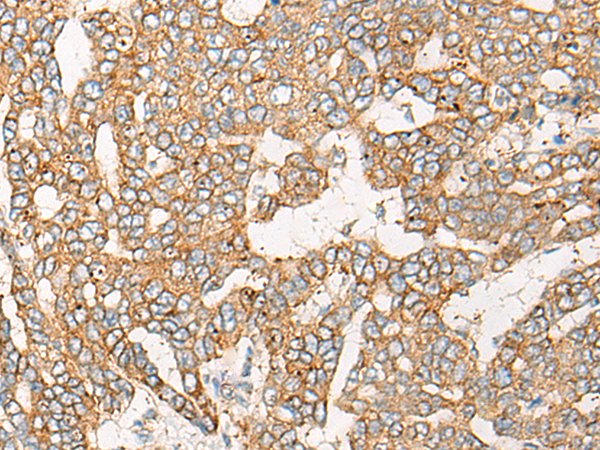

|
Background: |
The genes CHKB and CPT1B are adjacent on chromosome 22 and read-through transcripts are expressed that include exons from both loci. The read-through transcripts are candidates for nonsense-mediated mRNA decay (NMD) and are unlikely to express proteins. |
|
Applications: |
ELISA, IHC |
|
Name of antibody: |
CHKB-CPT1B |
|
Immunogen: |
Fusion protein of human CHKB-CPT1B |
|
Full name: |
CHKB-CPT1B readthrough (NMD candidate) |
|
Synonyms: |
CHKL-CPT1B |
|
SwissProt: |
Q92523 |
|
ELISA Recommended dilution: |
5000-10000 |
|
IHC positive control: |
Human liver cancer and Human gastric cancer |
|
IHC Recommend dilution: |
25-100 |

購物車
購物車 幫助
幫助
 021-54845833/15800441009
021-54845833/15800441009
